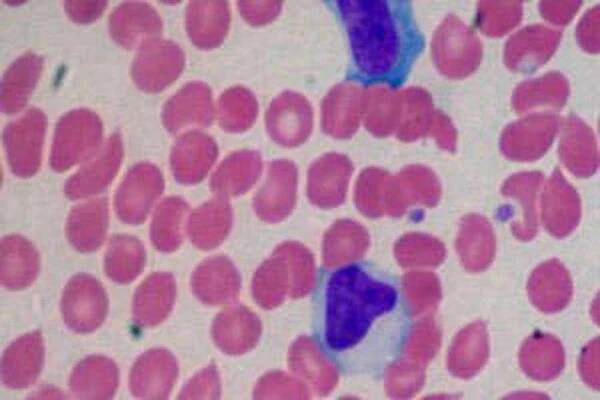

Test EBV z krve | Mononukleóza - Vyšetření mononukleózy z krve
Nechte si udělat krevní test na protilátky EBV - mononukleóza. Výsledky už do pár dnů.
Odborné informaceVíce než 3500+ hodnoceníLaboratorní diagnostikaDárkové poukazy
Havířská 1821/51b, Karviná
…onemocnění, vysoké teploty, často i dlouhotrvající, s nulovou reakcí na případnou antibiotickou terapii. Kromě teploty jsou velmi časté bolesti hlavy, svalů, bolesti v krku s obtížným a bolestivým polykáním a bolestivé zduřelé uzliny. Objevují se dále zažívací obtíže, bolesti břicha, nevolnost a nechutenství.
Infekční mononukleóza – Wikipedie
Nejvážnější komplikací s mononukleózou spojenou je kromě ME/CFS také vážné poranění sleziny, ke kterému dojde v méně než jednom procentu případů. [4 ]
Mononukleóza: příznaky, diagnóza a léčba | Pilulka.cz
Mononukleóza je zákeřné i celkem časté onemocnění, které lze zaměnit s angínou. Na Pilulka.cz si můžete zjistit informace o příznacích i průběhu léčby.
Mononukleóza a její vliv na játra: Příznaky, léčba a prevence…
Mononukleóza, známá jako "nemoc z líbání", je virové onemocnění způsobené virem Epstein-Barrové (EBV). Nejčastěji postihuje dospívající a mladé dospělé, ale může zasáhnout i děti a dospělé.
Mononukleóza – příznaky, přenos a léčba | EUC.cz | EUC
Mononukleóza je infekční virové onemocnění, které se nejčastěji projevuje v pubertě a u dětí. Provází ji únava, zvětšené uzliny na krku a angínové příznaky.
Jak se projevuje mononukleóza?
Onemocnění se nejčastěji objevuje v pubertě nebo u dětí a projevuje se velkou únavou, zvětšenými lymfatickými uzlinami na krku či v podpaží, zvětšením jater a sleziny a také příznaky typickými pro angínu. Diagnostiku mononukleózy stanovuje lékař.Jak se přenáší mononukleóza?
Přenos mononukleózy probíhá nejčastěji přenosem slin, i proto se jí přezdívá polibková nemoc nebo nemoc z líbání. K přenosu mononukleózy může ale dojít také při darování krve nebo transfuzi.Jak dlouho je mononukleóza infekční
Nakažlivost mononukleózy hrozí po celou dobu inkubační doby, tedy asi 4 týdny od začátku onemocnění.Mononukleóza - Dr. Popov
K dalším příznakům často patří zvýšená teplota, opakované angíny (mandle potažené bílým povlakem), lehké postižení jater, krátkodobá žloutenka, zvětšení sleziny.
Zákeřná Mononukleóza: Jak poznat skrytou hrozbu? – Dáma.cz
Bolí vás v krku, jste unavení, máte zduřené uzliny na krku? Dost možná jde o infekční mononukleózu – virové onemocnění, které se přenáší mimo jiné líbáním.
Co je mononukleóza, jak se přenáší a jak poznat její příznaky…
Infekční mononukleóza , často přezdívaná „ nemoc z líbání “, není to jen tak časově omezená nepříjemnost. Ovlivňuje děti i dospělé, její příznaky mohou být zavádějící, protože připomínají běžná virová onemocnění, ale také závažná a její…
4.8 (99+)Cena od 33 Kč
odkazuje na služby nejen od Seznam.cz.
© 1996–2025 Seznam.cz, a.s.